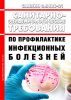
СанПиН 3.3686-21 Санитарно-эпидемиологические требования по профилактике инфекционных болезней 2025 год. Последняя редакция

- Артикул:00-01036722
- ISBN: 978-5-403080-76-7
- Обложка: Твердая обложка
- Издательство: ЦЕНТРМАГ (все книги издательства)
- Город: Москва
- Страниц: 1056
- Формат: А5 (148x210 мм)
- Год: 2025
- Вес: 1390 г
Документ продается с актуализацией на дату продажи!
Постановление Главного государственного санитарного врача РФ от 28.01.2021 N 4 "Об утверждении санитарных правил и норм СанПиН 3.3686-21 "Санитарно-эпидемиологические требования по профилактике инфекционных болезней"
Настоящие санитарные правила и нормы разработаны с целью предупреждения возникновения и распространения инфекционных болезней среди населения Российской Федерации.
Документ отменяет:
СП 3.3.2.1288-03 Надлежащая практика производства медицинских иммунобиологических препаратов, СП 1.2.1318-03 Порядок выдачи санитарно-эпидемиологического заключения о возможности проведения работ с возбудителями инфекционных заболеваний человека I - IV групп патогенности (опасности), генно-инженерно-модифицированными микроорганизмами, ядами биологического происхождения и гельминтами, СП 3.5.1378-03 Санитарно-эпидемиологические требования к организации и осуществлению дезинфекционной деятельности, СП 3.1.2260-07 Порядок учета, хранения, передачи и транспортирования материалов, инфицированных или потенциально инфицированных диким полиовирусом, СП 3.4.2318-08 Санитарная охрана территории РФ, СП 1.3.2322-08. Безопасность работы с микроорганизмами III - IV групп патогенности (опасности) и возбудителями паразитарных болезней, СП 3.1.1.2341-08 Профилактика вирусного гепатита В, СП 3.3.2342-08 Обеспечение безопасности иммунизации, СП 3.1.3.2352-08 Профилактика клещевого вирусного энцефалита, СП 3.3.2367-08 Организация иммунопрофилактики инфекционных болезней, СП 3.1.1.2521-09 Профилактика холеры. Общие требования к эпидемиологическому надзору за холерой на территории Российской Федерации, СП 3.1.7.2616-10 Профилактика сальмонеллеза, СП 3.1.7.2615-10 Профилактика иерсиниоза, СП 3.1.7.2614-10 Профилактика геморрагической лихорадки с почечным синдромом, СП 3.1.7.2613-10 Профилактика бруцеллеза, СП 3.1.2.2626-10 Профилактика легионеллеза, СП 3.1.7.2627-10 Профилактика бешенства среди людей, СП 3.1.7.2629-10 Профилактика сибирской язвы, СП 3.1.7.2642-10 Профилактика туляремии, СП 3.1.7.2811-10 Профилактика коксиеллеза (лихорадка Ку), СП 3.1.7.2815-10 Профилактика орнитоза, СП 3.1.7.2817-10 Профилактика листериоза у людей, СП 3.1.7.2816-10 Профилактика кампилобактериоза среди людей, СП 3.1.2825-10 Профилактика вирусного гепатита A, СП 3.1.5.2826-10 Профилактика ВИЧ-инфекции, СП 3.1.7.2835-11 Профилактика лептоспирозной инфекции у людей, СП 3.1.2950-11 Профилактика энтеровирусной (неполио) инфекции, СП 3.1.2951-11 Профилактика полиомиелита, СП 3.1.2952-11 Профилактика кори, краснухи и эпидемического паротита, СП 3.1.7.3107-13 Профилактика лихорадки Западного Нила, СП 3.1.1.3108-13 Профилактика острых кишечных инфекций, СП 3.1.2.3109-13 Профилактика дифтерии, СП 3.2.3110-13 Профилактика энтеробиоза, СП 3.1.3112-13 Профилактика вирусного гепатита C, СП 3.1.2.3113-13 Профилактика столбняка, СП 3.1.2.3116-13 Профилактика внебольничных пневмоний, СП 3.1.2.3117-13 Профилактика гриппа и других острых респираторных вирусных инфекций, СП 1.3.3118-13 Безопасность работы с микроорганизмами I-II групп патогенности (опасности), СП 3.1/3.2.3146-13 Общие требования по профилактике инфекционных и паразитарных болезней, СП 3.1.2.3149-13 Профилактика стрептококковой (группы А) инфекции, СП 3.1.7.3148-13 Профилактика Крымской геморрагической лихорадки, СП 3.1.2.3162-14 Профилактика коклюша, СанПиН 3.2.3215-14 Профилактика паразитарных болезней на территории Российской Федерации, СП 3.5.3.3223-14 Санитарно-эпидемиологические требования к организации и проведению дератизационных мероприятий, СП 3.1.3263-15 Профилактика инфекционных заболеваний при эндоскопических вмешательствах, СП 3.1.3310-15 Профилактика инфекций, передающихся иксодовыми клещами, СП 3.3.2.3332-16 Условия транспортирования и хранения иммунобиологических лекарственных препаратов, СП 3.1.7.3465-17 Профилактика чумы, СанПиН 3.5.2.3472-17 Санитарно-эпидемиологические требования к организации и проведению дезинсекционных мероприятий в борьбе с членистоногими, имеющими эпидемиологическое и санитарно-гигиеническое значение, СП 3.1.1.3473-17 Профилактика брюшного тифа и паратифов, СП 3.1.3525-18 Профилактика ветряной оспы и опоясывающего лишая, СП 3.1.3542-18 Профилактика менингококковой инфекции
Содержание
СанПиН 3.3686-21. Санитарные правила и нормы "Санитарно-эпидемиологические требования по профилактике инфекционных болезней"
I. Область применения
II. Общие требования по профилактике инфекционных болезней
III. Санитарно-эпидемиологические требования к организации и осуществлению дезинфекционной, дератизационной и дезинсекционной деятельности
IV. Санитарно-эпидемиологические требования к обеспечению безопасности при работе с ПБА
V. Санитарная охрана территории Российской Федерации
VI. Профилактика ВИЧ-инфекции
VII. Профилактика вирусных гепатитов B и C
VIII. Профилактика туберкулеза
IX. Профилактика инфекций, передающихся кровососущими комарами
X. Профилактика инфекций, передающихся иксодовыми клещами
XI. Профилактика сибирской язвы
XII. Профилактика чумы
XIII. Профилактика бруцеллеза
XIV. Профилактика лептоспироза
XV. Профилактика туляремии
XVI. Профилактика орнитоза
XVII. Профилактика коксиеллеза (Лихорадка Ку)
XVIII. Профилактика крымской геморрагической лихорадки
XIX. Профилактика геморрагической лихорадки с почечным синдромом
XX. Профилактика клещевого вирусного энцефалита
XXI. Профилактика лихорадки Зика
XXII. Профилактика бешенства
XXIII. Профилактика лихорадки Западного Нила
XXIV. Профилактика острых кишечных инфекций
XXV. Профилактика холеры
XXV. Профилактика холеры
XXVI. Профилактика сальмонеллеза
XXVII. Профилактика брюшного тифа и паратифов
XXVIII. Профилактика листериоза
XXIX. Профилактика иерсиниоза
XXX. Профилактика кампилобактериоза
XXXI. Профилактика вирусного гепатита A и E
XXXII. Профилактика полиомиелита
XXXIII. Профилактика энтеровирусной (неполио) инфекции
XXXIV. Профилактика гриппа и других острых респираторных вирусных инфекций
XXXV. Профилактика кори, краснухи, эпидемического паротита
XXXVI. Профилактика ветряной оспы и опоясывающего лишая
XXXVII. Профилактика коклюша
XXXVIII. Профилактика дифтерии
XXXIX. Профилактика менингококковой инфекции
XL. Профилактика внебольничных пневмоний
XLI. Профилактика стрептококковой (группы A) инфекции
XLII. Профилактика легионеллеза
XLIII. Профилактика паразитарных болезней на территории Российской Федерации
XLIV. Профилактика инфекций, связанных с оказанием медицинской помощи
XLV. Профилактика столбняка
XLVI. Организация иммунопрофилактики инфекционных болезней
XLVII. Обеспечение безопасности иммунизации
XLVIII. Условия транспортирования и хранения иммунобиологических препаратов
Приложение 1. ПБА по группам патогенности
Приложение 2. Обеспечение проведения обеззараживания при осуществлении работ с ПБА
Приложение 3. Обеспечение безопасности при работе с ПБА в части использования рабочей одежды и средств индивидуальной защиты
Приложение 4. Обеспечение безопасности при работе с ПБА в части эксплуатации инженерно-технических систем
Приложение 5. Контрольный лист учета инструктажей по биологической безопасности (Рекомендуемый образец)
Приложение 6. Эффективность дезинфекционных средств, учитываемая при организации проведения дезинфекционных мероприятий
Приложение 7. Рекомендуемые образцы
Таблица 1. Журнал регистрации патогенных биологических агентов, объектов (проб, образцов), поступивших для исследования
Таблица 2. Журнал учета выделенных штаммов микроорганизмов
Таблица 3. Журнал учета движения патогенных биологических агентов
Таблица 4. Журнал учета движения патогенных биологических агентов (расширенная форма журнала)
Таблица 5. Инвентарный журнал коллекционных патогенных биологических агентов
Таблица 6. Журнал выдачи патогенных биологических агентов
Таблица 7. Карта индивидуального учета коллекционного патогенного биологического агента
Таблица 8. Журнал учета ПБА I-IV групп, находящихся в рабочей коллекции штаммов
Таблица 9. Журнал консервации патогенных биологических агентов
Таблица 10. Журнал обеззараживания патогенных биологических агентов
Таблица 11. Журнал регистрации вскрытия первичной емкости (ампулы, флакона) с сухим патогенным биологическим агентов I-II групп с целью высева или уничтожения
Таблица 12. Журнал регистрации уничтожения ПБА I-IV групп, (культур, штаммов микроорганизмов и вирусов)
Таблица 13. Акт передачи патогенных биологических агентов I-II групп внутри подразделения и ПБА III-IV групп (культур, штаммов микроорганизмов и вирусов) внутри организации
Таблица 14. Акт передачи патогенных биологических агентов I-II групп между подразделениями внутри организации
Таблица 15. Акт передачи патогенных биологических агентов I-IV групп патогенности на (после) временное (ого) хранение (я) внутри подразделения организации
Таблица 16. Акт передачи патогенных биологических агентов I-IV групп патогенности на (после) временное (ого) хранение (я) между подразделениями организации
Таблица 17. Акт передачи патогенных биологических агентов I-IV групп за пределы организации
Таблица 18. Паспорт штамма
Приложение 8. Упаковка, маркировка, документация для транспортировки ПБА I - IV групп патогенности (опасности), классифицируемых как грузы 6-го класса опасности
Приложение 9. Классификация и идентификация ПБА I - IV групп патогенности (опасности) для целей транспортировки
Приложение 10. Разрешение о возможности транспортирования патогенного(ых) биологического(их) агента(ов), не включенных в список микроорганизмов, токсинов, оборудования и технологий, подлежащих экспортному контролю (Рекомендуемый образец)
Приложение 11. Перечень инфекционных болезней, требующих проведения мероприятий по санитарной охране территории Российской Федерации
Приложение 12. Определение степени риска для контактных лиц при выявлении на транспортных средствах лиц с подозрением на опасные инфекционные болезни и проведение профилактических мер в отношении контактных лиц
Приложение 13. Контингенты, подлежащие обязательному медицинскому освидетельствованию на ВИЧ-инфекцию и рекомендуемые для добровольного обследования на ВИЧ-инфекцию
Приложение 14. Журнал учета аварийных ситуаций при проведении медицинских манипуляций (Рекомендуемый образец)
Приложение 15. Акт о медицинской аварии в учреждении (Рекомендуемый образец)
Приложение 16. Контингенты, подлежащие обязательному обследованию на наличие HBsAg в сыворотке (плазме) крови
Приложение 17. Контингенты, подлежащие обязательному обследованию на наличие ANTI-HCV в сыворотке (плазме) крови
Приложение 18. Контингенты, подлежащие обязательному обследованию на наличие ANTI-HCV IGG и РНК вируса гепатита C в сыворотке (плазме) крови
Приложение 19. Дифференцирование территории Российской Федерации при проведении мероприятий по профилактике чумы
Приложение 20. Районирование административных территорий Российской Федерации по типам эпидемических проявлений холеры
Приложение 21. Контингенты населения, подлежащие лабораторному обследованию на холеру
Приложение 22. Коды для окончательной классификации случаев заболеваний с синдромом острого вялого паралича (в соответствии с МКБ-10)
Приложение 23. Карта эпидемиологического расследования случая полиомиелита и острого вялого паралича (Рекомендуемый образец)
Приложение 24. Ежемесячный отчет о регистрации полиомиелита и острых вялых параличей и вирусологических исследованиях на полио и энтеровирусы (Рекомендуемый образец)
Приложение 25. Ежегодный список всех зарегистрированных случаев полиомиелита и острых вялых параличей (ОВП) (Рекомендуемый образец)
Приложение 26. Направление на лабораторное (вирусологическое) исследование проб фекалий от больного полиомиелитом, острым вялым параличом (Рекомендуемый образец)
Приложение 27. Акт уничтожения материалов, инфицированных или потенциально инфицированных диким, вакцинным и вакцинородственным полиовирусом (Рекомендуемый образец)
Приложение 28. Акт передачи материалов, инфицированных или потенциально инфицированных диким, вакцинным и вакцинородственным полиовирусом, за пределы организации (Рекомендуемый образец)
Приложение 29. Карта эпидемиологического расследования случая заболевания краснухой или подозрительного на эту инфекцию (Рекомендуемый образец)
Приложение 30. Карта эпидемиологического расследования случая заболевания корью или подозрительного на эту инфекцию (Рекомендуемый образец)
Приложение 31. Сведения о заболевших корью, краснухой и эпидемическим паротитом в разных возрастных группах (Рекомендуемый образец)
Приложение 32. Основные группы дезинфицирующих препаратов и методов, используемых для предотвращения контаминации легионеллами и обеззараживания потенциально опасных водных систем
Приложение 33. Концентрации Legionella pneumophila в отдельных объектах
Приложение 34. Журнал контроля обработки эндоскопов для нестерильных вмешательств (Рекомендуемый образец)
Приложение 35. Дезинвазия объектов окружающей среды в очаге энтеробиоза
Приложение 36. Санитарно-паразитологические исследования объектов внешней среды
Приложение 37. Журнал контроля стерилизации эндоскопического оборудования ручным способом (Рекомендуемый образец)
Приложение 38. Схема уровней "Холодовой цепи"
Приложение 39. Журнал регистрации температуры в холодильном оборудовании (Рекомендуемый образец)
Приложение 40. Журнал учета движения ИЛП (Рекомендуемый образец)
Артикул 00576983